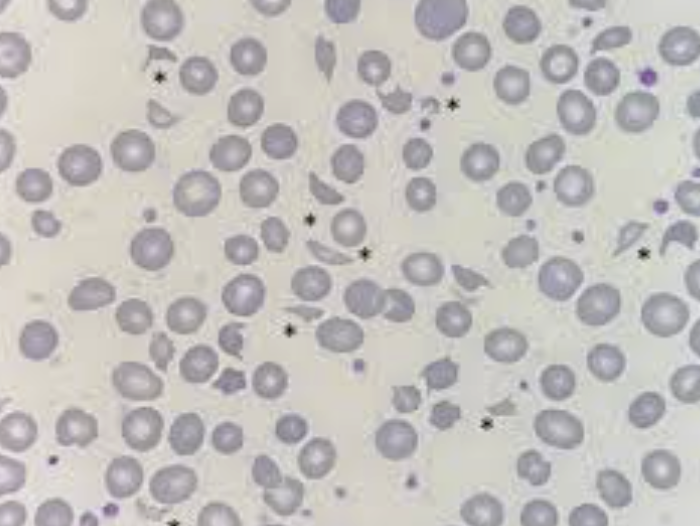

1
Q
¿Qué es?
A
Generación excesiva y anormal de trombina y fibrina en la sangre
2
Q
¿CID explosiva?
A
Neoplasias: LPA (M3)
3
Q
Etiologías más importantes
A
- Sepsis GN
- Obstétricas
- Neoplasias
- Autoinmunidad
- Trauma masivo
4
Q
⭐️ muy preguntado
Alteraciones de laboratorio en CID
A
- TP, TTPA y TT prolongados
- Fibrinógeno ↓
- Factores de coagulación ↓
- AT-III ↓
- PDF ↑ y Dímero D ↑
4
Q
Clínica inicial y tardía de CID
* Inicial
* Tardía
A
- Trombosis, microangiopatía
- Hemorragias generalizadas
5
Q
Hallazgos en extensión de sangre periférica
A
- Esquistocitos
- Trombocitopenia
6
Q
Etiología CID aguda vs crónica
* Aguda:
* Crónica:
A
- Sepsis, obstétricos
- Neoplasias
7
Q
Tx
Tx para CID crónica
A
HBPM
8
Q
Tratamiento de CID
A
Tratar causa base (lo más importante)
8
Q
Tx
Si el sangrado o descenso severo…
A
Plasma fresco o plaquetas
9
Q
TP, TTPA y TT prolongados + leucopenia + trombopenia ¿Dx + probable?
A
CID aguda


